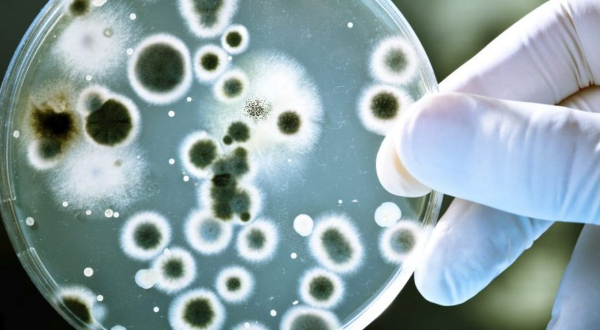

Za šta se koriste antibiotici?
Antibiotici se naširoko koriste za ubijanje bakterija i inhibiciju njihova rasta. Prirodni biljni antibiotici su najbolji jer imaju minimalne ili nikakve nuspojave.
Također pomažu u borbi protiv bakterija koje su postale otporne na određene propisane antibiotike. Postoji veliki popis voća, povrća, eteričnih ulja i biljaka koji su poznati po svojim antimikrobnim svojstvima. (Tekst se nastavlja ispod)
Prirodni biljni antibiotici
Češnjak
Kulture širom svijeta odavno su prepoznale češnjak zbog njegovih preventivnih i ljekovitih svojstava. Istraživanja su otkrila da se češnjak može boriti protiv raznih oblika bakterija uključujući salmonelu i escherichia coli (E. coli)
Ehinacea
Ehinaceja ponovno postaje popularna jer istraživanja potvrđuju da je učinkovita u liječenju mnogih sojeva mikroorganizama, kao i da djeluje protuupalno. Djelujući prvenstveno kao imunološki modulator, Echinacea modulira imunološku funkciju protiv bakterijskih, gljivičnih i virusnih infekcija.
Istraživanja pokazuju da je posebno učinkovit protiv infekcija gornjih dišnih putova, sinusitisa, prehlade, virusnih infekcija sličnih gripi, stafilokoka, streptokoka, kandide i herpes virusa.
Kada ehinaceja najbolje djeluje?
Ehinaceja najbolje djeluje kod prvih znakova infekcije, pomaže smanjiti simptome i trajanje infekcije. Ako ste osjetljivi na bilo koju od gore navedenih infekcija, Echinacea se može koristiti kao preventivni tretman, kako bi se smanjio razvoj infekcije prije nego što počne.
Manuka
Na Novom Zelandu svi smo čuli za dobrobiti Manuka meda, ali znate li što čini med tako posebnim? To je izvorni Manuka. Pčele oprašuju Manuka grm i proizvod ima jača antibiotska svojstva od bilo koje druge vrste meda.
Tradicionalno se Manuka koristila za snižavanje vrućice, kao sedativ, sredstvo protiv bolova i za pomoć pri urinarnim stanjima. Po svojoj prirodi djeluje antimikrobno i protuupalno, Manuka je učinkovit tretman protiv bakterijskih, gljivičnih i infekcija helmintima, groznice i prehlade.
Kako nam manuka pomaže?
Manuka može biti učinkovita protiv rasta streptokoknih bakterija koje uzrokuju upalu grla, pomaže kod astme, bronhitisa i problema sa sinusima te uklanja infekcije jačanjem imunug sistema.
Ulje divljeg origana
Ulje divljeg origana, dobiveno iz lišća divljeg origana, prije svega djeluje kao antioksidans, ali budući da sadrži i velike količine aktivnog spoja karvakrola, ima izrazito jako antibakterijsko djelovanje. Koristi se za liječenje respiratornih infekcija, kao što je upala nosne sluznice i sinusa, te za običnu prehladu i kašalj.
Odlično je i za liječenje rana povezanih s infekcijom, ali i za liječenje mokraćnih infekcija, pogotovo onih povezanih s mjehurom. Ulje divljeg origana osim toga djeluje i na viruse i neke vrste gljivica.
Kadulja
Kadulja je poznata po svom antibakterijskom i antivirusnom djelovanju. Izrazito učinkovito smiruje upale pogotovo usne šupljine, pa se ne koristi samo za liječenje upale grla nego i za upalu desni. Čaj od kadulje najbolje je grgljati, a pije se vrlo oprezno jer u većim količinama može štetno djelovati na jetru.
Neem
Neem je priznata ljekovita biljka poznata po svom antibakterijskom svojstvu. Drvo neema raste u Indiji, a njegovo se ulje u ajurvedskoj medicini koristi više od 2000 godina. Neem ulje se obično koristi u borbi protiv bakterijskih infekcija kože, kao što su dermatitis i akne.
Bosiljak
Bosiljak je biljka koja se najčešće nalazi u svakom indijskom vrtu. U studiji provedenoj među devet eteričnih ulja, ulje bosiljka pokazalo je najjače antimikrobno svojstvo protiv različitih bakterija uključujući S. Enteritidis, bakteriju koja ozbiljno utječe na ljude uzrokujući gastrointestinalne probleme. (Tekst se nastavlja ispod)
Prirodni antibiotik
Propolis je već odavno dobro poznati prirodni antibiotik koji štiti od bakterija i jača imunitet. Za razliku od običnih antibiotika, propolis djeluje i na viruse.
Istraživanja pokazuju, da uzimanje propolisa u sezoni gripe i prehlade smanjuje rizik od oboljenja od ovih bolesti čak za 53%. Propolis je učinkovit i u liječenju kašlja, upale grla, sinusa i krajnika.




**mitolyn**
Mitolyn is a carefully developed, plant-based formula created to help support metabolic efficiency and encourage healthy, lasting weight management.